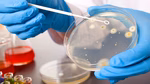
thumbnail

Svijet nije spreman
Milioni ljudi ugroženi zbog širenja smrtonosnih gljivica

Gljivice koje uzrokuju infekcije i odgovorne su za milione smrti godišnje značajno će se proširiti na nove regije kako se planet zagrijava, predviđaju nova istraživanja - a svijet nije spreman.
Oglas
Klimatske promjene donose sa sobom neočekivane prijetnje. Naučnici sa Univerziteta u Manchesteru upozoravaju da bi opasne gljivice poput Aspergillusa mogle značajno proširiti svoj areal u budućnosti, ugrožavajući milione života.
Gljivične infekcije, koje već sada godišnje ubijaju oko 2,5 miliona ljudi, mogu postati još opasnije zbog otpornosti na lijekove i promjena u klimatskim uvjetima. Odmah se nameće pitanje – jesmo li spremni?
Opasne gljivice na maršu: Klimatske promjene stvaraju idealne uvjete
Kako se planet zagrijava, Aspergillus flavus i Aspergillus fumigatus šire se prema sjeveru. Ove gljivice ne samo da ugrožavaju ljudsko zdravlje, već mogu izazvati i gubitke u poljoprivredi, čineći ih dvostrukom prijetnjom.
- Aspergillus flavus već sada pokazuje otpornost na antifungalne lijekove.
- Aspergillus fumigatus mogao bi povećati svoje širenje za 77,5% do 2100. godine.
- Pogođene regije: Sjeverna Amerika, Kina, Rusija, Europa.
Kako se zaštititi?
Za sada nema jednostavnog rješenja, ali stručnjaci naglašavaju važnost:
- Praćenja klimatskih promjena i prilagodbi zdravstva
- Razvoja novih antifungalnih lijekova
- Jačanja otpornosti imunološkog sistema kroz prevenciju i edukaciju
╰┈➤ Program N1 televizije možete pratiti UŽIVO na ovom linku kao i putem aplikacija za Android /iPhone/iPad
Kakvo je tvoje mišljenje o ovome?
Učestvuj u diskusiji ili pročitaj komentare
Oglas
Kakvo je tvoje mišljenje o ovome?
Učestvuj u diskusiji ili pročitaj komentare
Oglas





 Srbija
Srbija
 Hrvatska
Hrvatska
 Slovenija
Slovenija